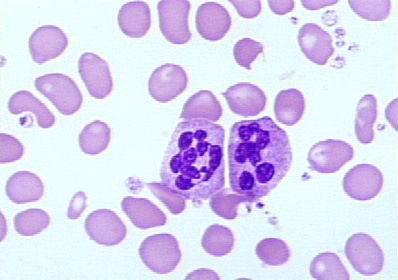
toks-zernist-nejtr-3-398x280.jpg

Токсическая зернистость нейтрофилов как диагностический фактор
Виды токсических изменений нейтрофилов
Чтобы охарактеризовать тяжесть токсических изменений нейтрофилов, используют определенную классификацию. Для этого врачами была разработана система так называемых плюсов. Система классификации поражений оценивает размер гранул, образовавшихся в больных клетках, а также количество больных клеток в условных процентах:
- Токсическая зернистость В«плюсВ» — обнаруживается мелкая, то есть В«пылеобразнаяВ» зернистость.
- Диагноз В«два плюсаВ» констатируется в случае, если зернистость имеет средние размеры, а количество патологических клеток — около половины.
- Зернистость +++ — в клетках крупные измененные зерна. Клетки поражены на 75%.
- Если же анализ показывает ++++, это означает, что есть тяжелое угрожающее заболевание клеток крови, при этом в них имеются крупные гранулы, а цитоплазма разреженная.
Кроме того, различают следующие типы изменений:
- Собственно зернистость.
- Структуры Деле, имеющие изменчивые размеры и формы и окрашенные в светлый синий оттенок.
- Вакуолизация — формирование вакуолей в плазме клеток. Такое бывает при опасных заболеваниях (сепсисе) или при лейкоцитозе. Может сочетаться с элементами Деле и с другими патологиями.
- Гиперсегментация — появление в ядре клеток более пяти сегментов. Такое бывает при мегалобластной анемии. Редко может наблюдаться у здоровых людей (особая наследственная особенность).
Виды токсической зернистости нейтрофильных гранулоцитов
Для определения тяжести морфологических изменений лейкоцитарных гранулоцитов используют специальную классификацию – систему плюсов. Она позволяет оценить характер дегенеративных изменений, количество патологических клеток в процентном соотношении от всего объема лейкоцитарных гранулоцитов. Виды патологической зернистости нейтрофильных гранулоцитов:
- Токсическая грануляция + характеризуется наличием мелкой «пылеобразной» грануляции.
- Два плюса означают, что грануляция имеет средние величины, а количество больных нейтрофилов в крови составляет больше половины.
- Токсическая зернистость с тремя плюсами характеризуется большими видоизменными гранулами. Порядка 80% нейтрофилов при расстройстве имеют дегенеративные морфологические изменения.
- При четырех плюсах практически все клетки деформированы. Зачастую данное расстройство заканчивается летальным исходом, поэтому требует неотложного вмешательства специалистов.
Помимо вышеперечисленных изменений в препарате крови наблюдается пять основных особенностей токсического изменения нейтрофильных гранулоцитов:
- Цитоплазматическая базофилия.
- Цитоплазматическая вакуоляция.
- Присутствие телец Деле.
- Незрелость ядер в клетках.
- Токсическое гранулирование.
Норма
Норма токсической зернистости нейтрофилов это когда она отсутствует, но существуют условно патологические состояния, при которых дегенерация в клетках присутствует незначительная и требует лишь наблюдения до нормализации состава лейкоцитарной формулы. К таким состояниям можно отнести беременность, послеоперационный период, период окончательного выздоровления после тяжелой гнойно-септической инфекции.
Диагностика
Токсическую зернистость не всегда можно обнаружить при обычном окрашивании, поэтому для ее выявления применяются специальные методы, а именно метод окрашивания Фрейфельд. В этом случае применяют фуксин и раствор метиленового синего.
Для приготовления первого красителя один грамм фуксина помещают в 96% этиловый спирт (15 грамм) и нагревают до растворения. После того как остынет, добавляют 5% раствор карболовой кислоты в количестве 100 мл. Семь капель первого красителя добавляют в 20 мл воды и перемешивают, затем добавляют второй краситель (1% раствор синего метиленового) в количестве пяти капель и снова перемешивают. Приготовленной смесью красят мазки крови в течение часа, после чего смывают водой и сушат. Если ранее производилось окрашивание по Романовскому, метод Фрейфельд можно применять без предварительного обесцвечивания.
После окрашивания можно наблюдать сиреневую зернистость в виде пыли или хлопьев, что зависит от тяжести заболевания. В результате анализа обычно указывают размер гранул, то есть зернистость может быть пылевидной, мелкой, средней, крупной, в виде хлопьев, и количество нейтрофилов (на сто клеток) с токсогенной зернистостью в процентах.
Крупная токсическая зернистость нейтрофилов
Кроме этого, при диагностике нужно:
- рассчитать лейкоцитарную формулу;
- выявить общее число лейкоцитов;
- установить, имеют ли лейкоциты патологические изменения;
- определить уровень юных форм нейтрофилов.
Образование дегенеративных изменений
Токсическая зернистость нейтрофилов, что это означает и какая причина. В норме клетка нейтрофила в крови содержит мельчайшие включения – зернышки. При наличии сильного воспалительного процесса, сопровождающегося выделением гнойного экссудата, в клетках тканей происходят изменения. Под воздействием инфекционного агента происходят физико-химические реакции, приводящие к сворачиванию белка в крови и присоединению его к естественным зернам клетки.
Таким образом, с одной стороны, нарастает калибр деформированной зернистости и количество, с другой – происходит разряжение цитоплазмы, т.е. цитоплазма клетки нейтрофила теряет свою насыщенность из-за коагуляции белка.
Дегенеративные изменения чаще появляются раньше ядерного сдвига и могут служить предупреждением ухудшения состояния и угрозы развития негативных последствий.
Частые вопросы
Какие изменения происходят в нейтрофилах при токсической зернистости?
При токсической зернистости нейтрофилов происходит увеличение размера и изменение структуры их гранул, что может быть связано с наличием в организме инфекции или воспаления.
Какова роль токсической зернистости нейтрофилов в диагностике заболеваний?
Токсическая зернистость нейтрофилов может служить важным диагностическим фактором, указывая на наличие инфекции, воспаления или других патологических процессов в организме.
Какие методы используются для оценки токсической зернистости нейтрофилов?
Для оценки токсической зернистости нейтрофилов могут применяться методы микроскопии крови, автоматизированные анализаторы крови, а также специальные окраски и методы исследования гранулярной структуры нейтрофилов.
Полезные советы
СОВЕТ №1
При обнаружении токсической зернистости нейтрофилов в крови следует обратить внимание на возможное наличие инфекционного процесса в организме. Токсическая зернистость нейтрофилов может быть связана с бактериальными или вирусными инфекциями, поэтому необходимо провести дополнительное обследование для выявления возможного источника инфекции.
СОВЕТ №2
При наличии токсической зернистости нейтрофилов в крови рекомендуется провести дифференциальный диагноз с другими возможными причинами, такими как лекарственная токсичность, острые воспалительные процессы, острые кровопотери и другими патологиями. Это позволит установить точный диагноз и назначить соответствующее лечение.


Что такое гипосегментация и Пельгеровская аномалия нейтрофилов
Если незрелые гранулоциты повышены — что это может значить?
О чем говорят незрелые гранулоциты в анализе крови
Норма нейтрофилов в крови у детей
Сегментоядерные нейтрофилы крови: нормальные показатели и причины отклонений от нормы
Гранулоциты - это что такое?